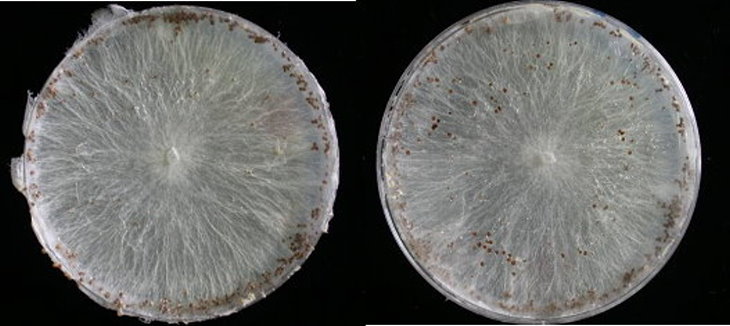
病原菌型態：白絹病在PDA培養基上之型態，白色菌絲上有褐色菌核。

收件日期:990407
發生地點:臺東豐里分場
病蟲害名稱:甜菊(白絹病)
病徵判斷

地際部葉片呈黃褐色水浸狀病斑,維管束受阻導致莖部萎凋。
診斷結果
病原菌型態:白絹病在PDA培養基上之型態,白色菌絲上有褐色菌核。
防治方法
◎ 選用乾淨未帶菌之扦插苗床。
◎ 拔除病株集中燒燬,並移除地際部土壤,徹底清除病菌。
◎ 無機鹽類化合物如尿素、氰氮化鈣和亞硝酸鹽類均可抑制菌核發芽,甚或殺死菌核。
藥劑防治
◎ 50%脫克松可濕性粉劑1,000倍。
◎ 25%普克利乳劑1,000倍。
◎ 50%福多寧可濕性粉劑3,000倍。
◎ 75%滅普寧可濕性粉劑1,000倍。
◎ 50%益發靈可濕性粉劑1,000倍。
◎ 35%依得利可濕性粉劑1,500倍。
藥液應噴及栽培基質,噴藥後應停止噴水5~7天,菊花苗床不可行。



